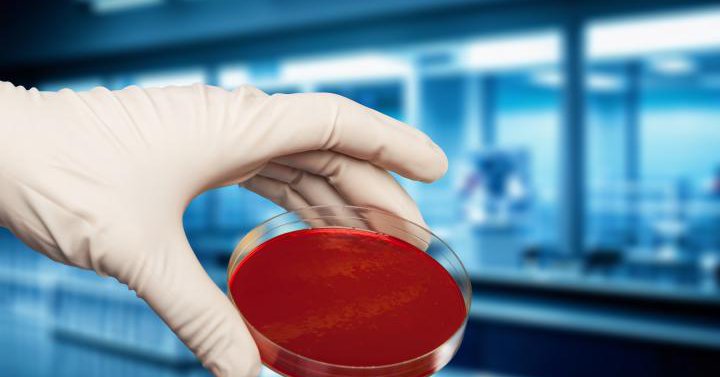
Tweet card summary image

Tech2Market Sp.zo.o.
@Tech2Market_pl
Followers
71
Following
1K
Media
23
Statuses
4K
Zapewniamy pełne wsparcie dla waszych projektów innowacyjnych. Consulting, strategy, EU projects. Member of AMAPOLA consortium @AMAPOLA_project
Busko-Zdrój, Polska
Joined May 2015
Zespół naszych naukowców opracował innowacyjną metodę automatycznej klasyfikacji gęstości zabudowy miejskiej z wykorzystaniem mikrofalowych obrazów satelitarnych SAR 🔍🔬 https://t.co/czXxYJH7gs
pw.edu.pl
Zespół naukowców z Politechniki Warszawskiej opracował innowacyjną metodę automatycznej klasyfikacji gęstości zabudowy miejskiej z wykorzystaniem mikrofalowych obrazów satelitarnych SAR (Synthetic...
0
1
3
Zespół informatyków z udziałem dwóch Polaków znalazł sposób na skokowe zwiększenie głębokości sieci neuronowych - z kilku do aż tysiąca warstw - w modelach AI uczenia ze wzmocnieniem (RL). Ich pracę nagrodzono na konferencji naukowej NeurIPS o AI. https://t.co/psWPQsb4tr
naukawpolsce.pl
Zespół informatyków z udziałem dwóch Polaków znalazł sposób na skokowe zwiększenie głębokości sieci neuronowych - z kilku do aż tysiąca warstw - w modelach AI uczenia ze wzmocnieniem (RL). Pracę...
0
1
8
What is meant by Innovation Cycles? From the first wave of textiles and water power in the industrial revolution to the internet in the 1990s, here are the six waves of innovation and their key breakthroughs. #infographic Source @VisualCap rt @antgrasso #innovation #Internet
0
2
4
Międzynarodowy zespół z udziałem naukowców z Uniwersytetu Jana Kochanowskiego w Kielcach @ujk_kielce stworzył lekki, elastyczny i dopasowany do pacjenta #gorset do leczenia skoliozy. https://t.co/QnJvOmMfiY
naukawpolsce.pl
Międzynarodowy zespół z udziałem naukowców z Uniwersytetu Jana Kochanowskiego (UJK) w Kielcach stworzył lekki, elastyczny i dopasowany do pacjenta gorset do leczenia skoliozy.
0
3
6
When surgeons repair tissues, they’re currently limited to mechanical solutions like sutures and staples, which can cause their own damage. Now, Tissium is offering surgeons a new solution based on a biopolymer technology first developed at MIT.
news.mit.edu
MIT spinout Tissium offers surgeons a new solution for suture-free nerve repair. The company’s flexible, biocompatible polymers conform to surrounding tissues, attaching to them in order to repair...
9
71
209
📢 Masz wpływ na przyszłość innowacyjnych materiałów! ✍️Weź udział w konsultacjach publicznych dot. Advanced Materials Act – Twoja opinia się liczy! 🗓️ Do 13/01/2026 👉 https://t.co/CKodbFP3TC
#AdvancedMaterials #HoryzontEU #HaveYourSay
0
1
2
Naukowcy z Uniwersytetu Stanforda wyleczyli myszy z cukrzycą typu I. Uczeni jednocześnie dokonali transplantacji komórek macierzystych krwi i komórek wysp trzustkowych od dawcy niepasującego immunologicznie. U myszy, które już chorowały na cukrzycę typu I doszło do całkowitego
2
5
20
🫂Badania i innowacje muszą być inkluzywne! Poznaj Support Package 5 z projektu @INSPIREquality_ – narzędzie do wdrażania podejścia Inclusive Gendered Innovation. ✅ Bezpłatne, dostępne dla wszystkich! 👉 Sprawdź: https://t.co/7Y7687EEPN
#RównośćDlaInnowacji
0
2
2
Polish scientists have developed a bone implant that could improve treatment for patients with weak bones, by delivering drugs directly to fracture sites, project leaders say. @OfLublin
https://t.co/LuKknOQSTp
scienceinpoland.pl
Polish scientists have developed a bone implant that could improve treatment for patients with weak bones, by delivering drugs directly to fracture sites, project leaders say.
0
2
1
A method for reducing the risk of infections in humans and animals by removing dangerous microorganisms from flat surfaces with cold plasma, has ben developed and patented by scientists from @Uniwersytet_GD, @GUMedGdansk and @PWr_Wroclaw . https://t.co/U623opRJVY
scienceinpoland.pl
A method for reducing the risk of infections in humans and animals by removing dangerous microorganisms from flat surfaces with cold plasma, has ben developed and patented by scientists from the...
0
1
2
Przełom: nowa cząsteczka w leczeniu osteoporozy? Osteoporoza, nazywana często zrzeszotnieniem kości, to choroba charakteryzująca się osłabieniem kości, przez co stają się one bardziej podatne na złamanie, również to niskoenergetyczne, występujące po upadku z wysokości własnego
5
3
23
Przedstawicielki BPK Zrównoważona Gospodarka na I Kongresie Nauka dla Przemysłu! 🔬🤝 Rozmawialiśmy o tym, jak skutecznie łączyć naukę z biznesem, wspierać transfer technologii i rozwijać innowacje dzięki Horyzontowi Europa. Dziękujemy za wszystkie inspirujące spotkania!🌿✨
0
2
2
💎 PRZEŁOMOWE ODKRYCIE blokada pojedynczego białka zmusza komórki raka płuca do „samobójstwa". . 🔹STRESZCZENIE: Naukowcy odkryli sposób na walkę z jednym z najgroźniejszych nowotworów. Kiedy zablokowali specjalne białko o nazwie FSP1 w komórkach raka płuca, te przestały się
50
484
2K
Nanoparticles that continue to glow in infrared light after the light source is turned off could improve drug tracking in the body, physicists from Wrocław report. https://t.co/FgE6Orpn8k
0
1
2
Naukowcy z Politechniki Lubelskiej i Uniwersytetu Medycznego w Lublinie opracowali innowacyjny implant z minerałów znanych dotąd głównie z przemysłu, a teraz mających realną szansę odmienić leczenie osteoporozy - zapowiada PL. "Badacze połączyli siły, aby stworzyć materiał,
1
1
9
Nasi #naukowcy 👩🔬🧑🔬 uczestniczą w projekcie, którego celem jest opracowanie technologii umożliwiającej bezpośrednią konwersję biogazu w zielony wodór i cenne materiały węglowe w reaktorze katalitycznym nowej generacji 🧪 https://t.co/Xai1oTXA2d
pw.edu.pl
Naukowcy z Politechniki Warszawskiej uczestniczą w jednym z najbardziej innowacyjnych projektów badawczych w Europie. Celem przedsięwzięcia jest opracowanie technologii umożliwiającej bezpośrednią...
0
2
6
Polskie innowacyjne firmy otrzymają dofinansowanie. Wartość programu Innovate Poland może sięgnąć nawet kilkunastu miliardów złotych. https://t.co/DZBeULAYEH
@MF_GOV_PL @Domanski_Andrz @GrupaPZU #BogdanBenczak
0
1
1
Nasi przedstawiciele wśród laureatów konkursu "Innowator Mazowsza" 👏 https://t.co/pgXDb4DVud
pw.edu.pl
Znamy nazwiska zwycięzców tegorocznej edycji konkursu "Innowator Mazowsza". Nagradzane są w nim przełomowe projekty odpowiadające na kluczowe wyzwania współczesnego świata. W gronie Innowatorów...
0
1
5
Sztuczna inteligencja wkracza w obszar gospodarki odpadami. Technologia pomaga usprawnić cały proces i poprawić jakość recyklingu. https://t.co/C71E8fUhaj
#Globtrak #SławomirPrasek @ComtegraSA #DariuszSkonieczny
0
1
3